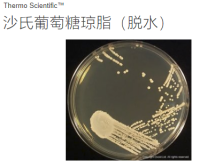
Thermo Scientific™ Oxoid™ 沙氏葡萄糖琼脂（脱水）CM0041B

相关产品推荐更多 >

Neogen Megazyme Product Price 产品价格表
¥2135
Thermo Scientific™ Oxoid™ Antibiotic Medium No. 3 Assay Broth CM0287B
¥1292
Thermo Scientific™ Oxoid™ Alternative Thioglycollate Broth CM0391B
¥1196
Thermo Scientific™ Oxoid™ Selenite Broth Base (Lactose)(Dehydrated) CM0395B
¥516
Thermo Scientific™ Oxoid™ 沙氏葡萄糖琼脂(脱水)CM0041B
¥374
万千商家帮你免费找货
0 人在求购买到急需产品
- 详细信息
- 技术资料
- 供应商:
Thermo Scientific
| 2019 Thermo Scientific M.I.C.E LIST | ||||
| 2019赛默飞M.I.C.E药敏检测条表 | ||||
| Part Number | Name | 浓度范围(μg/ml) | 包装规格 | Dealer Price(RMB) |
| MA0135D | 阿米卡星 | 256-0.015 | 10条 | |
| MA0109D | 阿莫西林(羟氨苄青霉素) | 256-0.015 | 10条 | |
| MA0107D | 阿莫西林/克拉维酸 | 256-0.015 | 10条 | |
| MA0110D | 氨苄西林 | 256-0.015 | 10条 | |
| MA0111D | 头孢噻肟(凯福隆) | 32-0.002 | 10条 | |
| MA0112D | 头孢噻肟(凯福隆) | 256-0.015 | 10条 | |
| MA0127D | 头孢洛林 | 32-0.002 | 10条 | |
| MA0120D | 头孢他啶 | 256-0.015 | 10条 | |
| MA0122D | 头孢曲松 | 32-0.002 | 10条 | |
| MA0104D | 环丙沙星(悉复欢) | 32-0.002 | 10条 | |
| MA0119D | 克林霉素(氯林可霉素,氯洁霉素) | 256-0.015 | 10条 | |
| MA0125D | 达托霉素 | 256-0.015 | 10条 | |
| MA0108D | 红霉素 | 256-0.015 | 10条 | |
| MA0116D | 庆大霉素 | 256-0.015 | 10条 | |
| MA0117D | 庆大霉素 | 1024-0.06 | 10条 | |
| MA0115D | 亚胺培南(泰能) | 32-0.002 | 10条 | |
| MA0113D | 左氧氟沙星(可乐必妥) | 32-0.002 | 10条 | |
| MA0106D | 利奈唑胺 | 256-0.015 | 10条 | |
| MA0121D | 美罗培南 | 32-0.002 | 10条 | |
| MA0103D | 甲硝唑(灭滴灵) | 256-0.015 | 10条 | |
| MA0126D | 莫匹罗星 | 1024-0.06 | 10条 | |
| MA0114D | 苯唑西林 | 256-0.015 | 10条 | |
| MA0100D | 青霉素G | 32-0.002 | 10条 | |
| MA0101D | 青霉素G | 256-0.015 | 10条 | |
| MA0118D | 替考拉宁 | 256-0.015 | 10条 | |
| MA0105D | 四环素 | 256-0.015 | 10条 | |
| MA0124D | 替加环素 | 256-0.015 | 10条 | |
| MA0102D | 万古霉素 | 256-0.015 | 10条 | |
风险提示:丁香通仅作为第三方平台,为商家信息发布提供平台空间。用户咨询产品时请注意保护个人信息及财产安全,合理判断,谨慎选购商品,商家和用户对交易行为负责。对于医疗器械类产品,请先查证核实企业经营资质和医疗器械产品注册证情况。
技术资料暂无技术资料 索取技术资料
2019赛默飞M.I.C.E药敏检测条Thermo Scientific M.I.C.E LIST
询价




